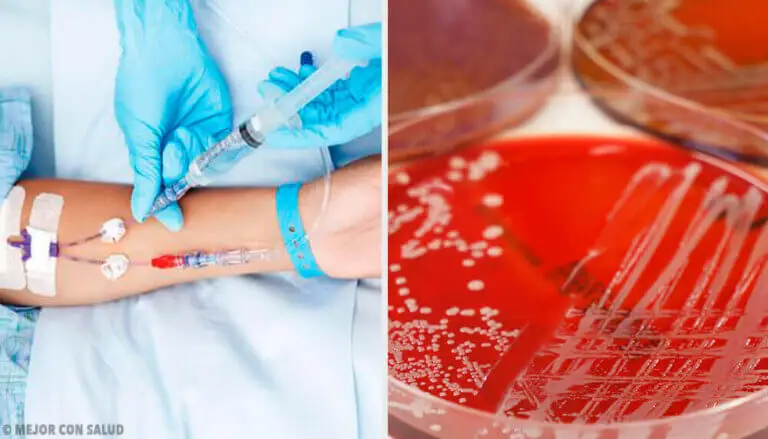

Cefalotina: qué es y cómo actúa

Revisado y aprobado por el biotecnólogo Alejandro Duarte
La cefalotina es un antibiótico perteneciente al grupo de cefalosporinas, en concreto, a las cefalosporinas de primera generación. Además de pertenecer a esta familia, la cefalotina se encuentra dentro de un grupo mayor de antibióticos denominado β-lactámicos.
Se trata de un antibiótico con propiedades similares a las penicilinas eficaz sobre todo frente bacterias gram+ gracias a un mecanismo de acción parecido. ¿Te lo han recetado alguna vez o sabes de alguien cercano a ti que lo haya tomado? Te contamos más al respecto a continuación.
Introducción: procedencia y estructura
La cefalotina, al igual que los demás antibióticos, es una sustancia producida por un ser vivo. La primera cefalosporina que se descubrió procede de las cepas de un hongo, el Cephalosporium acremonium en el 1948. Esto fue gracias a que el científico Giuseppe Brotzu había observado que las cepas de este hongo producían una sustancia eficaz frente a la salmonela
Después de más descubrimientos sobre estos antibióticos, se comercializó la primera cefalosporina, la cefalotina.
En cuanto a la estructura química de las cefalosporinas, son derivados del ácido 7-cefalosporánico que, al igual que la penicilina, tiene un anillo β-lactámico.
Además de esta estructura, presentan un anillo dihidrotiazínico, que a diferencia de las penicilinas, este está formado por 6 átomos y no por 5.
Descubre: Cómo actúan los antibióticos en las infecciones urinarias
Mecanismo de acción

La cefalotina tiene la capacidad de inhibir la síntesis de la pared celular de las bacterias. Esto lo consigue inhibiendo las etapas finales de la síntesis de péptidoglicano o mureína.
Bloquea la síntesis de esta estructura tanto en bacterias gram+ como en gram-. Esto lo consigue hacer desde la parte interna de la pared celular, es decir, que se tiene que colocar por dentro e inhibir un proceso. Este proceso es la transpeptidación que ocurre en los diferentes pasos de síntesis del péptidoglicano.
El hecho de que lo inhiban desde dentro implica que tiene que entrar y que tiene que atravesar la pared celular y eso justifica que sean fármacos más activos en bacterias Gram + porque la facilidad de paso es mayor, el acceso está facilitado.
Lo que aprovecha la cefalotina para entrar dentro de las bacterias gram- son esos canales o porinas. Como consecuencia de todo el proceso, da muerte a la bacteria, por lo que es un fármaco bactericida. Si no produjese la muerte y solamente inhibiese el crecimiento del microorganismo, se le denominaría bactericida.
Síntesis del peptidoglicano
La síntesis de esta estructura es un proceso muy complejo que ocurre en muchos pasos y que están marcados los distintos puntos donde van a actuar los diferentes antimicrobianos.
La cefalotina, por ser β-lactámico, actuará sobre un proceso posterior, inhibe un sistema enzimático que se encarga de la transpeptidación. Esta reacción se da una vez formado toda la adición de aminoácidos de distintos elementos para conformar finalmente la mureína o péptidoglicano.
Mecanismo de resistencia

Las bacterias tienen la capacidad te mutar para defenderse del ataque del fármaco y así mantenerse con vida. Si se abusa de la toma de antibióticos, las bacterias mutarán para hacerse resistentes y, ese fármaco dejará de hacer efecto.
En consecuencia, se deben desarrollar nuevos antibióticos con diferentes mecanismo de acción para conseguir el mismo efecto. El problema está en que esos recursos son limitados y es un proceso muy caro. Por ello, los antibióticos se deben tomar bajo prescripción médica y sin abusar de ellos, ya que no por tomar más van a ser más eficaces frente a la infección.
La prueba suprema de virtud consiste en poseer un poder ilimitado sin abusar de él.
-Thomas Macaulay-
Este proceso, en el caso de la cefalotina, puede surgir por tres mecanismos de resistencia:
- Mediante una enzima capaz de producir la hidrólisis enzimática del anillo β-lactámico. Estas enzimas se denominan β-lactamasas.
- Alterando los lugares de acción del antibiótico, que son las proteínas fijadoras de penicilinas.
- Bloqueando el transporte a través de la pared celular, sobre todo en bacterias gram-.
Reacciones adversas

La cefalotina es un fármaco que no se debe administrar en mujeres embarazadas, a menos que el beneficio supere los riesgos potenciales ya que no se dispone de estudios bien controlados.
Se han descrito reacciones adversas en diferentes sistemas del organismo. Por un lado, a nivel sanguíneo, la cefalotina puede desencadenar agranulocitosis, granulocitopenia y anemia hemolítica. En algunos pacientes también se ha observado trombocitopenia y pancitopenia. También se han descrito problemas gastrointestinales como:
- Diarrea
- Náuseas
- Vómitos
- Dolor abdominal
- Colitis pseudomembranosa
Además, puede producir o agravar una insuficiencia renal, en especial cuando se combina con otros agentes nefrotóxicos como la neomicina. Otros efectos adversos observados con cefalotina incluyen dolor en el sitio de inyección, fiebre medicamentosa y, al igual que otros antibióticos β-lactámicos, reacciones alérgicas que van desde erupción hasta el choque anafiláctico, aunque son poco frecuentes.
Todas las fuentes citadas fueron revisadas a profundidad por nuestro equipo, para asegurar su calidad, confiabilidad, vigencia y validez. La bibliografía de este artículo fue considerada confiable y de precisión académica o científica.
- Parra, M. M., Cardos, R. C., Esteva, P., Berlanga, M. R., Magaña, I. M., Saldaña, N. G., & Simental, P. S. (1999). Cefalotina amikacina vs. cefalotina isepamicina en el tratamiento inicial del paciente neutropénico febril. (Spanish). Revista de Enfermedades Infecciosas En Pediatria. https://doi.org/10.4172/2161-105X.1000221
Este texto se ofrece únicamente con propósitos informativos y no reemplaza la consulta con un profesional. Ante dudas, consulta a tu especialista.